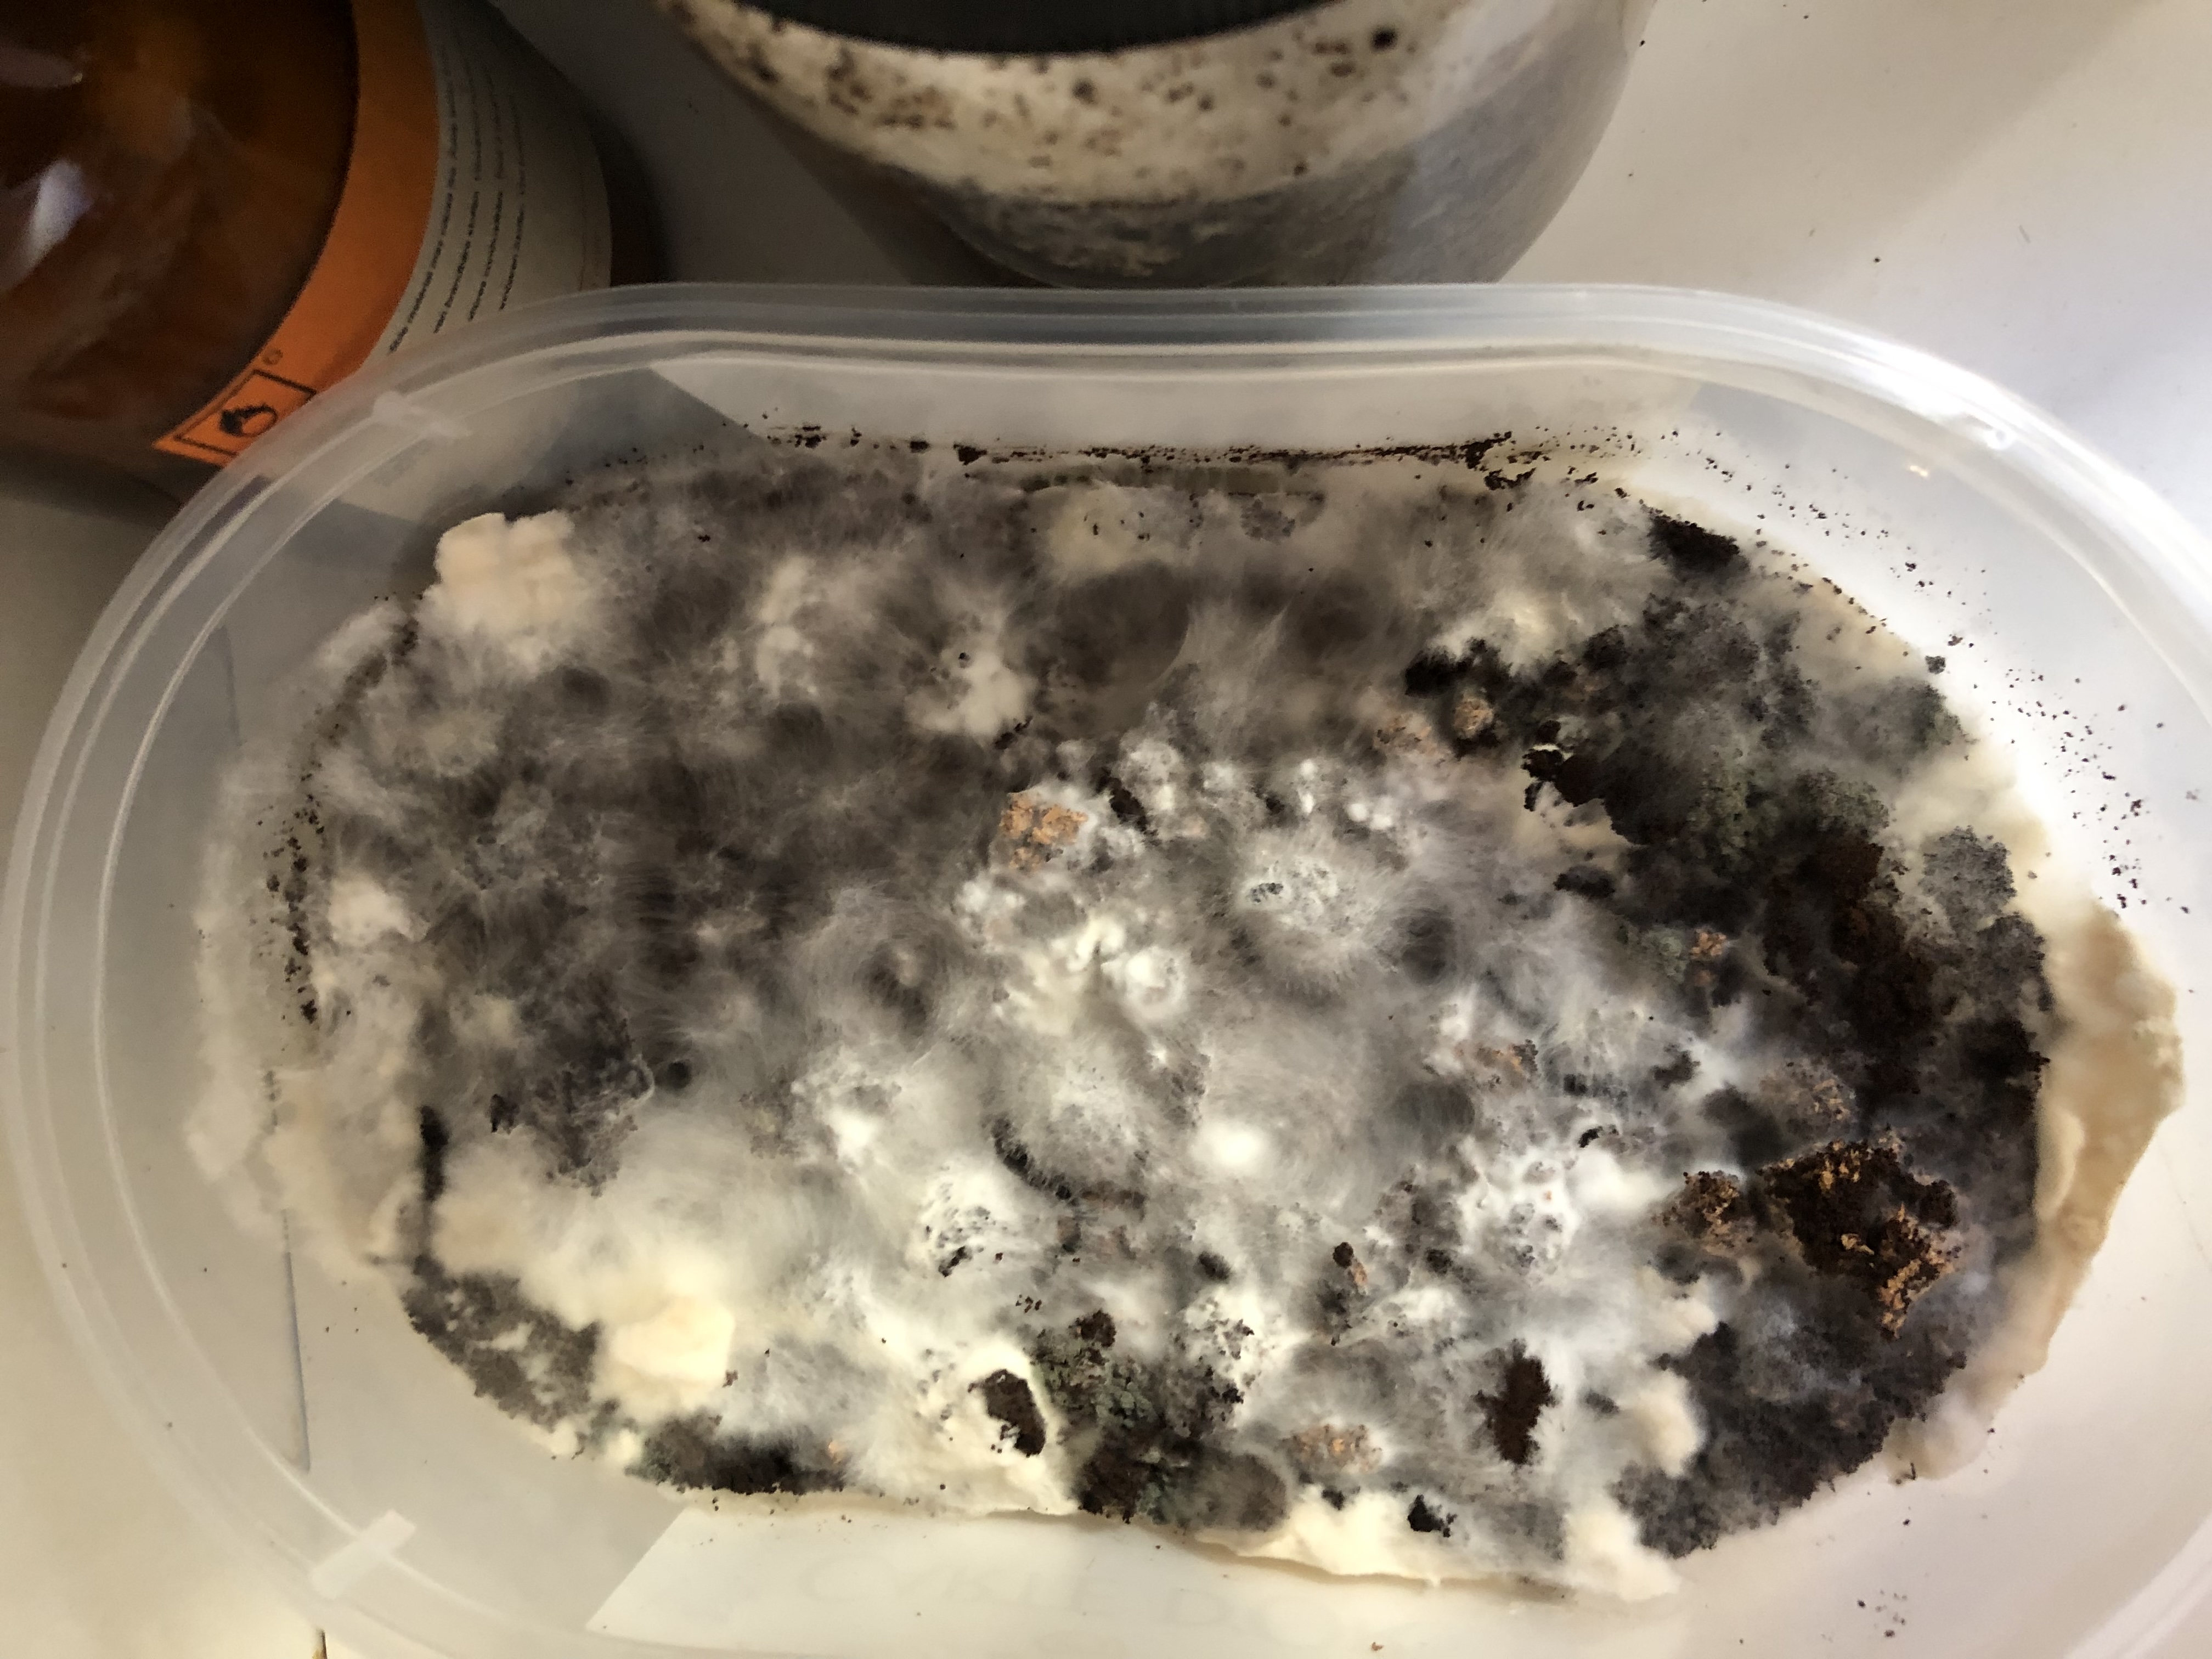

bild-20240611-164827-2d6ae34a.jpeg
Size of this preview: 800 × 600 pixels. Other resolutions: 403 × 302 pixels 1008 × 756 pixels 2016 × 1512 pixels 3024 × 2268 pixels 4032 × 3024 pixels
bild-20240611-164827-2d6ae34a.jpeg ( 4032 × 3024 pixels )
Information
| Date: | 2024/06/16 20:28 |
|---|---|
| Filename: | bild-20240611-164827-2d6ae34a.jpeg |
| Format: | JPEG |
| Size: | 2MB |
| Width: | 4032 |
| Height: | 3024 |
- report.txt
- Last modified: 2024/06/19 21:40
- by team1